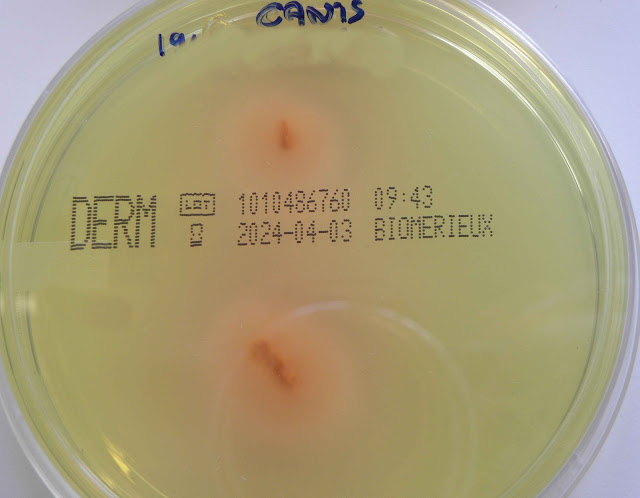
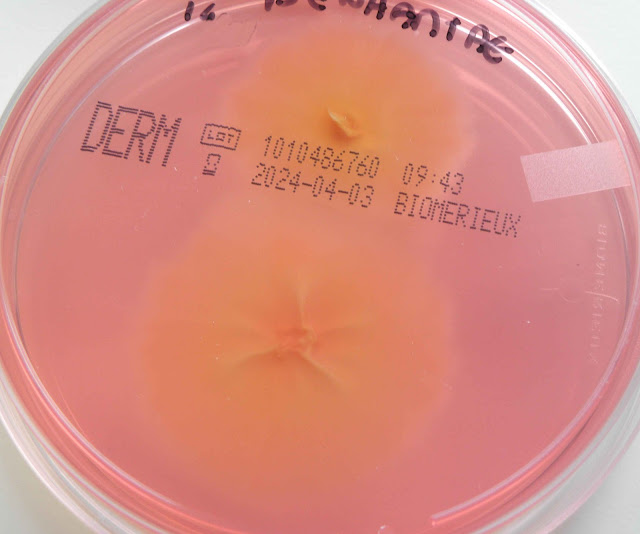

LABORATÓRIO MICOLOGIA
As fotografias deste atlas foram obtidos a partir de estirpes isoladas no laboratório de patologia clínica da unidade local de saúde de Coimbra; a maioria correspondem a casos clínicos que ocorreram na instituição e alguns são de estirpes adquiridas comercialmente. Esta unidade possui um hospital com praticamente todas as valências da medicina - internamento, urgência, hospital de dia e consultas.
O laboratório de micologia faz a identificação de fungos filamentosos através de uma abordagem clássica: informação clínica, observação macroscópica da colónia (velocidade de crescimento, cor, textura e morfologia da colónia em meio de sabouraud com cloranfenicol e gentamicina), e da observação de caraterística microscópicas do micélio. Dispõe de estufas a 25, 30 e 36 graus Celsius.
Os testes de sensibilidade aos anti-fungicos quer pelo método da microdiluição quer por tira de gradiente (E-Teste), são feitos apenas quando a evolução do caso clinico o justifique.
Para identificação de fungos leveduriformes possui aparelho para avaliação da proteómica (maldi-tof).
O serviço de patologia clínica também executa técnicas de biologia molecular como qPCR e sequenciação de Sanger para identificar estirpes problemáticas ou para elaboração de artigos científicos a publicar.
Para execução das pesquisas/identificação de fungos dermatófitos dispõe de um sistema de biologia molecular (euroarrayprocessor - "chip/array").
Para evidenciação indirecta da infeção fungica dispõe de um método de imunoensaio por difusão lateral para o galactomannan e para o antigénio de Cryptococcus. Está planeada a colocação, a breve prazo, de um aparelho automatizado para pesquisa de: (1-3) beta D glucan, galactomannan e antigénio de Cryptococcus.
Para pesquisa de Pneumocystis executa técnicas de imunofluorescência e de biologia molecular (qPCR).
O serviço de patologia clínica em colaboração com a farmácia do hospital disponibiliza estudos de farmacocinética/farmacodinâmica (doseamento de azóis) e farmacogenómica (perfil metabólico para voriconazol).